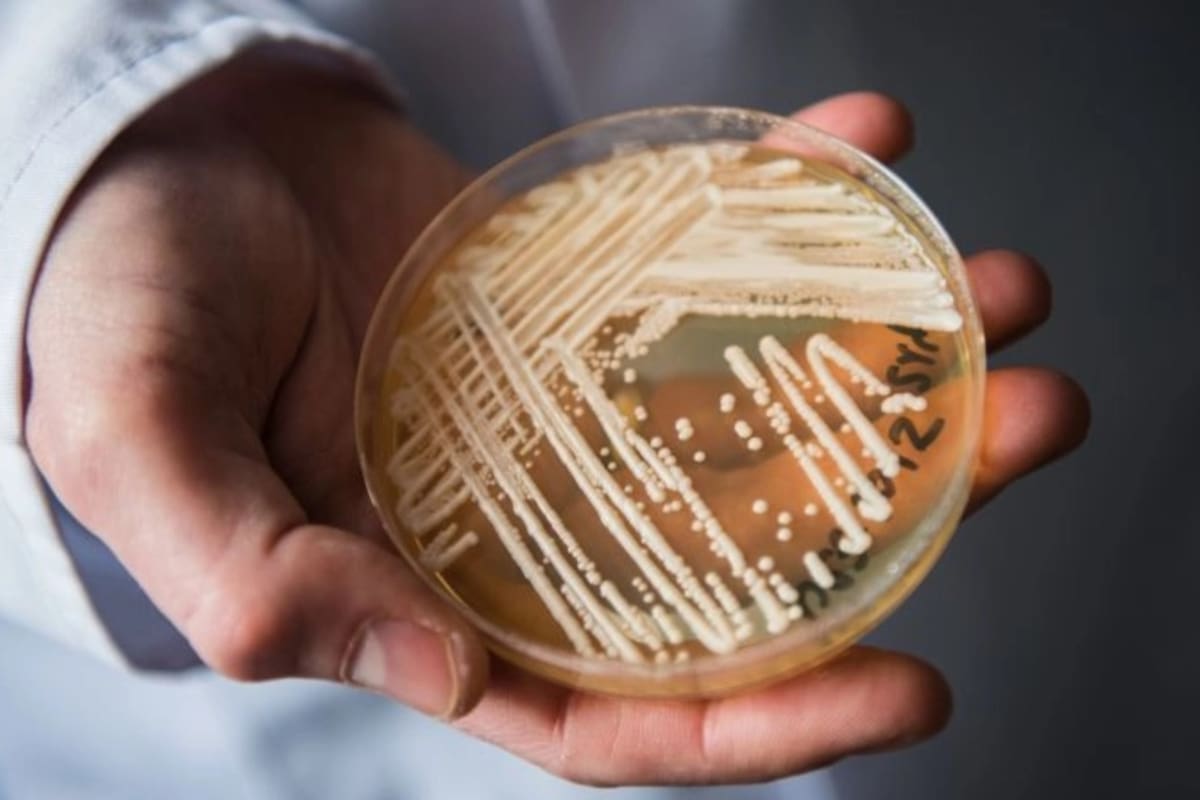
Los casos clínicos de Candida auris, un hongo emergente considerado una amenaza urgente, aumentaron considerablemente en los últimos años

La rápida propagación de un hongo mortal pone en alerta a las autoridades sanitarias en EE.UU.
Candida auris tiene una tasa de mortalidad de hasta el 60% y es particularmente riesgosa para las personas mayores o con sistemas inmunes comprometidos
7 minutos de lectura'
NUEVA YORK.- Un hongo mortal se está extendiendo rápidamente por Estados Unidos, lo que aumenta la presión para encontrar nuevos tratamientos para la enfermedad fúngica grave, señalaron investigadores federales norteamericanos.
Candida auris, un hongo descubierto hace unos 15 años en Japón, infectó al menos a 2377 personas en Estados Unidos en 2022, frente a las 53 de 2016, según los Centros para el Control y la Prevención de Enfermedades (CDC).
Su rápida propagación a la mayoría de los estados y a más de 40 países ha llevado a los CDC y a la Organización Mundial de la Salud a calificarlo de amenaza creciente para la salud pública. Candida auris tiene una tasa de mortalidad de hasta el 60% y es particularmente riesgosa para las personas mayores o con sistemas inmunes comprometidos. Según los CDD, se propagación se aceleró a un “ritmo alarmante” durante la pandemia.
Casi la mitad de los pacientes que contraen C. auris mueren en un plazo de 90 días, según los CDC. Pero la Dra. Meghan Lyman, médica de la rama de enfermedades micóticas de los CDC, explicó que la agencia no tenía una buena idea de cuántas muertes atribuir directamente al hongo. La razón es que las personas que se infectan también se enfrentan a otros múltiples problemas de salud, por lo que C. auris puede ser tanto una causa de muerte como algo que, junto con otros factores de mala salud, la acelera.

“Ver que una nueva especie aparece en escena y de repente se convierte en un patógeno mundial menos de 15 años después es realmente extraordinario”, afirmó el Dr. Peter Pappas, especialista en enfermedades infecciosas de la Universidad de Alabama en Birmingham.
La primera infección documentada por Candida auris en Estados Unidos se produjo en 2013, según un estudio de los CDC publicado el lunes en la revista Annals of Internal Medicine. Desde entonces, se han registrado casos de este hongo –que antes se limitaban sobre todo a las zonas de Nueva York y Chicago– en al menos 35 estados y Washington D.C.
“Ver el número de casos fue alarmante”, dijo Lyman.
C. auris no es una amenaza especial para los jóvenes sanos, cuyo sistema inmunitario puede combatirla, pero puede transportarse por la piel y la ropa. Quienes lo contraen pueden experimentar síntomas típicos de la infección, como fiebre y escalofríos que pueden intensificarse en ausencia de tratamiento.
El hongo suele afectar a pacientes de edad avanzada, sobre todo a los que acuden mucho o durante mucho tiempo a centros sanitarios, donde puede ser difícil de limpiar o erradicar. La mayor parte de la transmisión de Candida auris se ha producido en centros sanitarios que proporcionan cuidados a largo plazo a pacientes muy enfermos, según el documento.
El año pasado, el Select Specialty Hospital-Northwest Detroit, un centro de rehabilitación para enfermos graves, dejó temporalmente de admitir pacientes tras un brote de Candida auris.
Todos los centros sanitarios deben ser conscientes de la amenaza, afirmó Buddy Hammerman, director médico de Select Medical Holdings Corp, operador del hospital.
“Los pacientes están siendo infectados por este organismo y se está volviendo más listo que nosotros”, dijo el especialista.
El origen
Candida auris es una levadura de origen misterioso. Se identificó en 2009 tras descubrirse en el oído de un paciente en Japón. Los microbiólogos han rastreado las bases de datos genómicos y los entornos naturales en busca de pistas sobre su origen y evolución. Fuera de las personas, sólo se ha detectado en dos lugares: una marisma salada y una playa de arena de las islas Andamán, un remoto archipiélago del océano Índico.
Candida auris podría haber vivido en el medio ambiente o en los animales durante mucho tiempo antes de que un cambio estimulara su propagación en las personas, según afirman expertos en enfermedades infecciosas. El aumento de la temperatura global podría haber favorecido la evolución de la Candida auris hacia una mayor tolerancia al calor, haciéndola más apta para infectar a las personas, cuya temperatura corporal ha servido durante mucho tiempo como barrera eficaz contra las enfermedades fúngicas invasoras, señalaron. El uso generalizado de desinfectantes y antifúngicos en los cultivos podría haber favorecido la proliferación de Candida auris al eliminar a sus competidores microbianos.
Los desinfectantes comunes, como la lejía y el alcohol, no siempre son eficaces contra la Candida auris, que puede infectar la piel de una persona, indicó Andrej Spec, profesor asociado de medicina en la Facultad de Medicina de la Universidad de Washington en San Luis. Según Spec, para limitar su propagación se necesita una limpieza profunda y desinfectantes especiales que destruyan las esporas.
“Si se descubre que alguien tiene Candida auris en la piel, hay que aislarlo para evitar que infecte a otras personas”, añadió el experto.
Se calcula que las infecciones fúngicas matan al menos a 1,6 millones de personas al año, según Global Action for Fungal Infections, una organización sin ánimo de lucro dedicada a la investigación y la recaudación de fondos.
Resistencia
De acuerdo con el Dr. Spec, sólo existen tres clases de antifúngicos de uso común para las enfermedades fúngicas graves, y todos ellos pueden provocar efectos secundarios tóxicos. Además, los hongos están desarrollando resistencia a estos fármacos. Al menos siete infecciones por Candida auris fueron resistentes a los antifúngicos disponibles en 2021, dijeron los CDC, frente a cuatro en los años anteriores a 2020.
En 2020, según el documento de investigación, el 86% de las muestras de gérmenes analizadas por la Red de Laboratorios de Resistencia a los Antimicrobianos de los CDC eran resistentes a una clase de fármacos conocidos como azoles.
Más preocupante para las autoridades sanitarias es que el 1,2% de las muestras de C. auris eran resistentes ese año a una clase de fármacos de tratamiento de primera línea llamados equinocandinas. Si la resistencia a las equinocandinas se hace más común a medida que evoluciona el germen, el C. auris podría llegar a ser extremadamente difícil, si no imposible, de tratar, dijeron las autoridades sanitarias.
Scynexis y Pfizer están desarrollando fármacos que han demostrado en ensayos clínicos ser eficaces contra Candida auris. Cidara Therapeutics Inc. ha presentado su medicamento rezafungina a la Administración de Alimentos y Medicamentos (FDA) para su aprobación en el tratamiento de las infecciones por Candida, incluida la Candida auris. La rezafungina sería el primer fármaco nuevo para el tratamiento de las infecciones invasivas por Candida en más de una década, según la empresa.
Es probable que la pandemia de coronavirus haya agravado la propagación de C. auris, según los funcionarios de los CDC. Al centrarse la atención en el Covid-19, se hizo menos hincapié en la detección del C. auris. Además, el hongo tiende a adherirse a las batas de enfermería, los guantes y otros equipos de protección personal que, en condiciones ideales, se cambiarían con frecuencia, pero que se reutilizaron durante la pandemia debido a la escasez de suministros. C. auris también puede adherirse a respiradores u otros equipos médicos.
“Nos preocupaba lo que pudiera ocurrir durante el Covid”, afirmó Lyman.
Lyman también dijo que no todo son malas noticias. Los intensos esfuerzos por detener la propagación del germen en Nueva York e Illinois parecen haber sido eficaces a la hora de contener el C. auris dentro de los sistemas sanitarios de esos estados, incluso cuando el bicho arraigaba en otros lugares.
“No es una situación desesperada”, afirma Lyman.
Diarios The Wall Street Journal y The New York Times
1Agredieron al príncipe heredero exiliado de Irán, Reza Pahlavi, durante su aparición en Berlín
- 2
Bolivia y Chile buscan restablecer relaciones luego de medio siglo de distanciamiento
- 3
Irán exhibe su control sobre el estrecho de Ormuz tras el colapso de las negociaciones de paz
4Las fotos de las fiestas con deportistas que organizó la agencia investigada por prostitución y drogas en Italia






